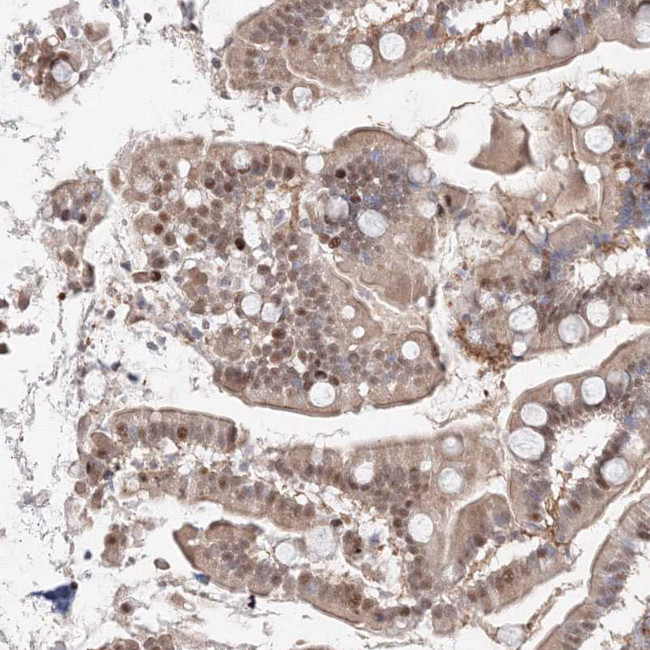
ARHGAP21 Antibody in Immunohistochemistry (Paraffin) (IHC (P))

Search
Invitrogen
ARHGAP21 Polyclonal Antibody
{{$productOrderCtrl.translations['antibody.pdp.commerceCard.promotion.promotions']}}
{{$productOrderCtrl.translations['antibody.pdp.commerceCard.promotion.viewpromo']}}
{{$productOrderCtrl.translations['antibody.pdp.commerceCard.promotion.promocode']}}: {{promo.promoCode}} {{promo.promoTitle}} {{promo.promoDescription}}. {{$productOrderCtrl.translations['antibody.pdp.commerceCard.promotion.learnmore']}}
产品信息
PA5-57742
种属反应
宿主/亚型
分类
类型
抗原
偶联物
形式
浓度
规格
纯化类型
保存液
内含物
保存条件
运输条件
RRID
产品详细信息
Immunogen sequence: VPPCLTTSAP LIRRQLSHDH ESVGPPSLDA QPNSKTERSK SYDEGLDDYR EDAKLSFKHV SSLKGIKIAD SQKSSEDSGS RKDSSSEVFS DAAKEG
Highest antigen sequence identity to the following orthologs: Mouse - 92%, Rat - 95%.
靶标信息
Functions as a GTPase-activating protein (GAP) for RHOA and CDC42. Downstream partner of ARF1 which may control Golgi apparatus structure and function. Also required for CTNNA1 recruitment to adherens junctions.
仅用于科研。不用于诊断过程。未经明确授权不得转售。
篇参考文献 (0)
生物信息学
蛋白别名: Rho GTPase-activating protein 10; Rho GTPase-activating protein 21; Rho-GTPase activating protein 10; Rho-type GTPase-activating protein 21; unnamed protein product
基因别名: ARHGAP10; ARHGAP21; KIAA1424
UniProt ID: (Human) Q5T5U3
Entrez Gene ID: (Human) 57584